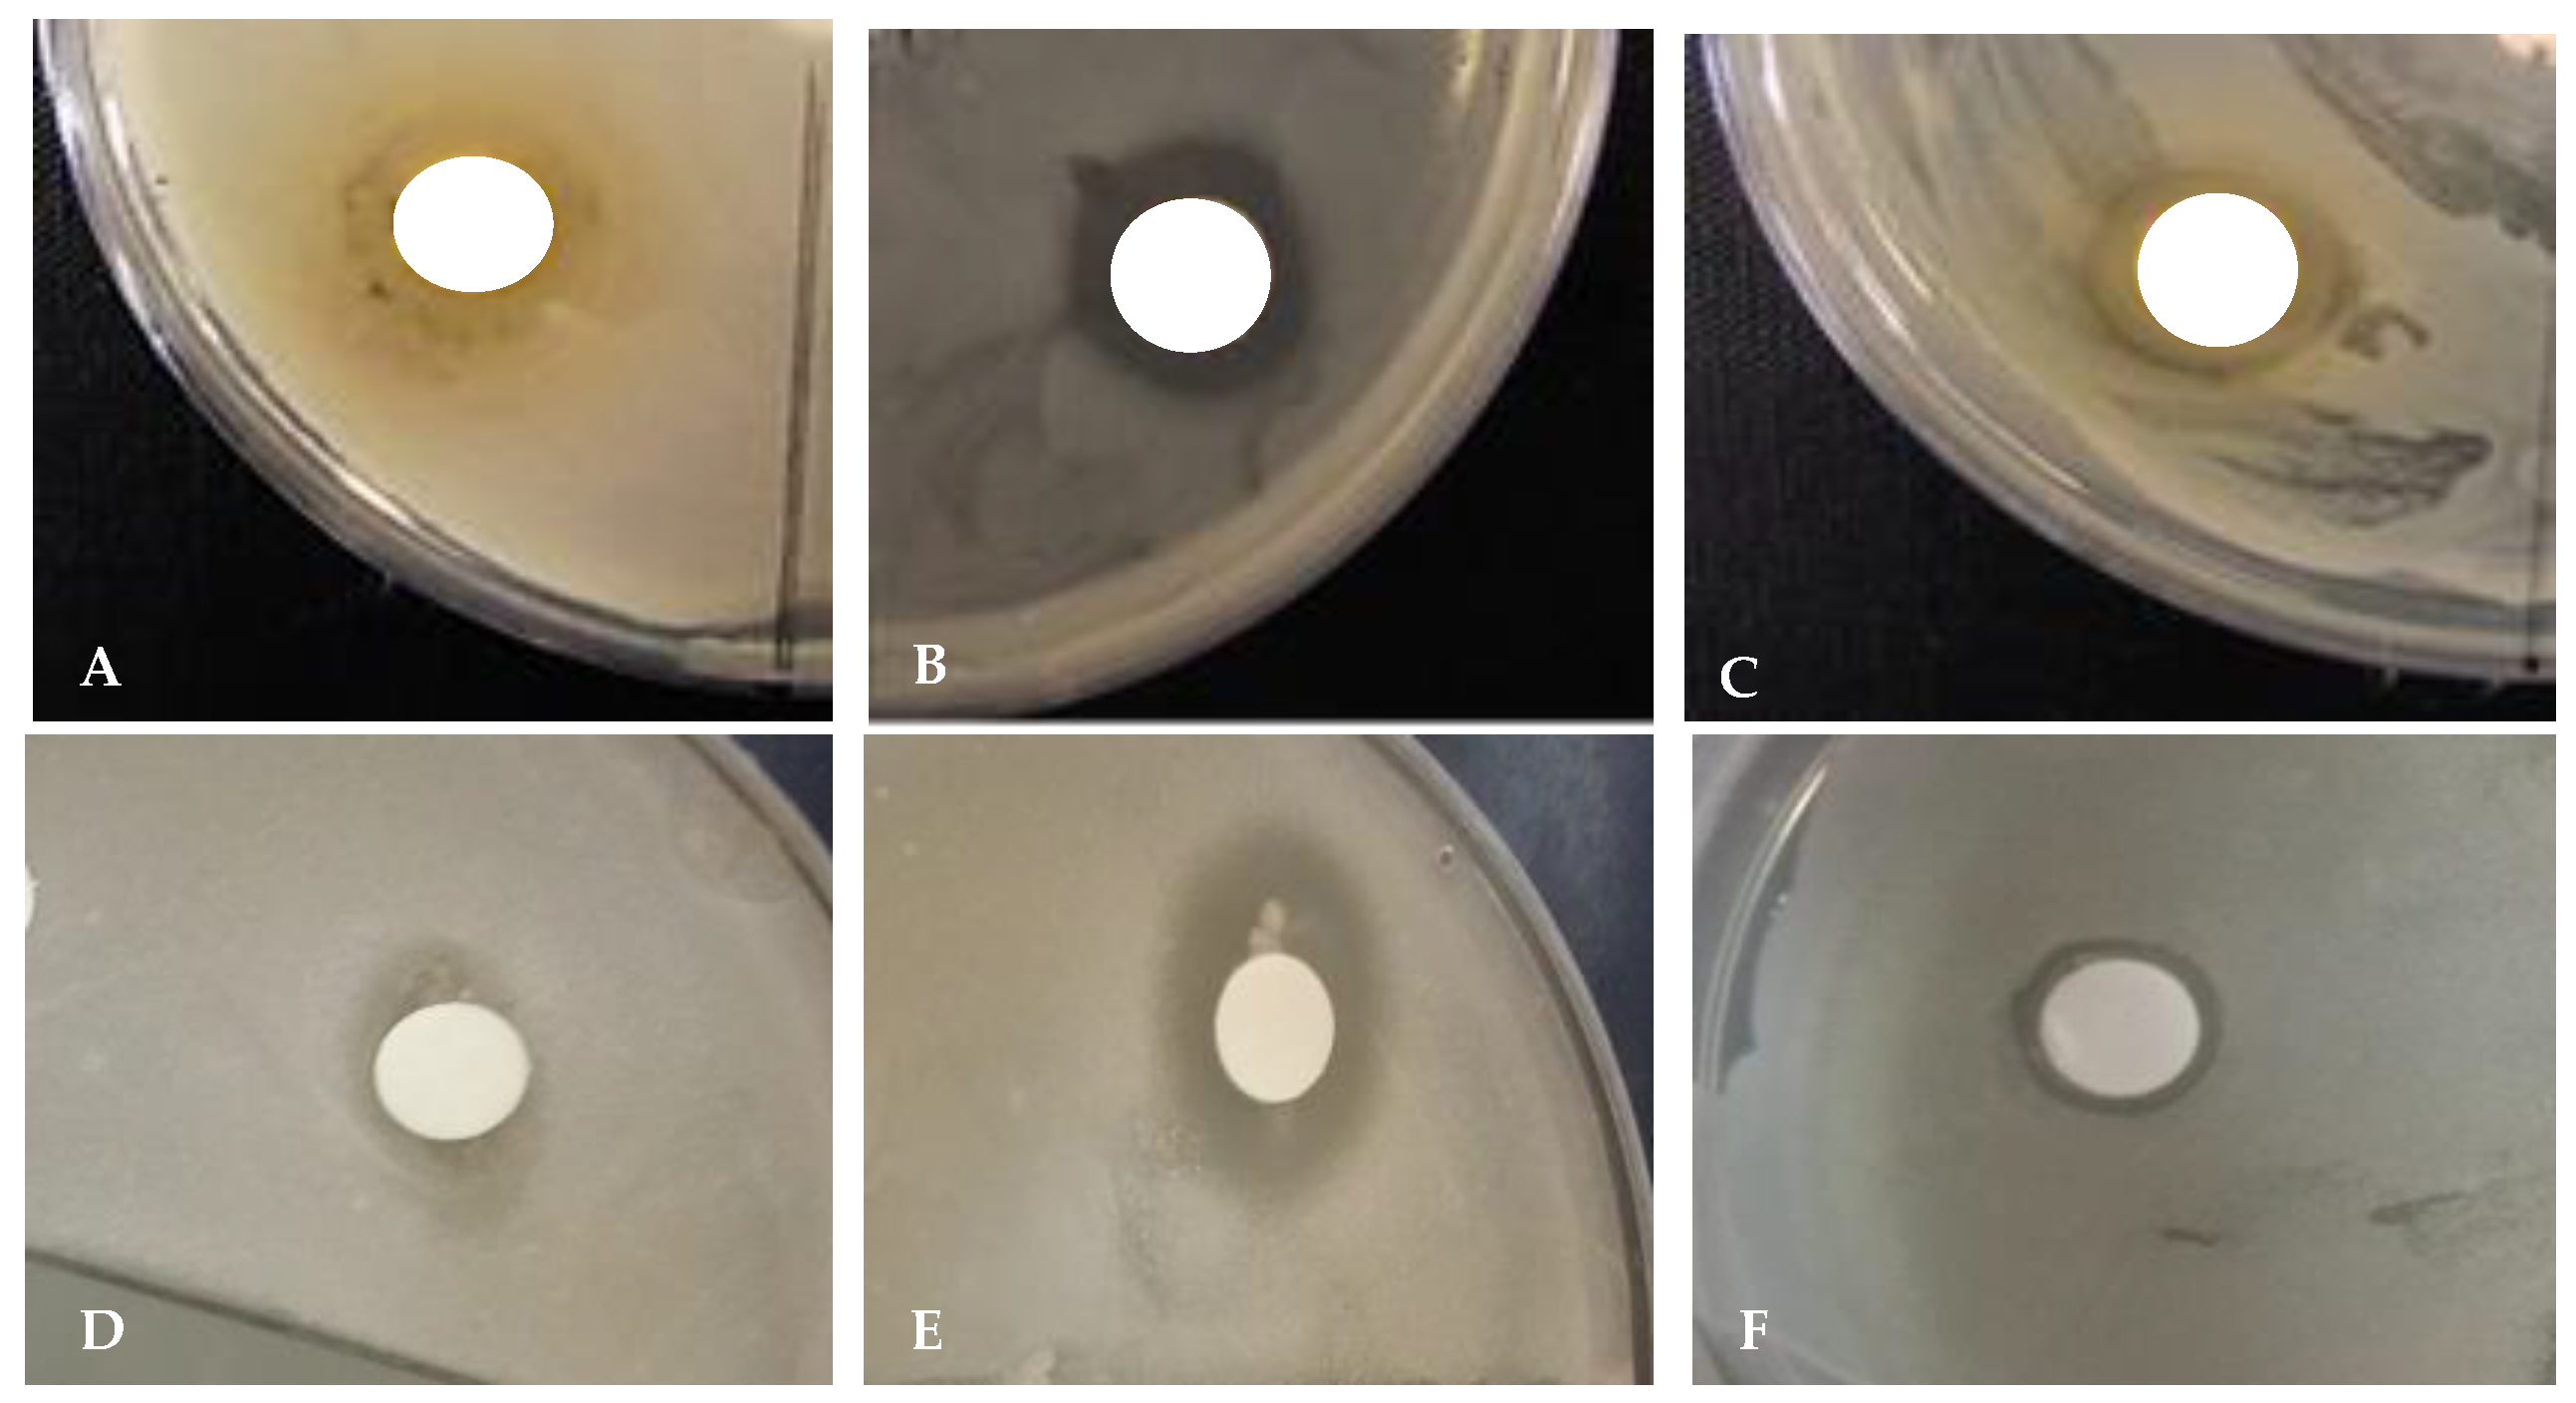

Assessment of Mineral and Phenolic Profiles and Their Association with the Antioxidant, Cytotoxic Effect, and Antimicrobial Potential of Lycium chinense Miller
Abstract
1. Introduction
2. Results and Discussion
2.1. Mineral Elements
2.2. Correlation between Antioxidant Properties and Minerals
2.3. The TPC, TFC, and Phenolic Compound Composition of L. chinense Leaf Extracts
2.4. Antioxidant Activity
2.5. Cytotoxic Effect
2.6. Irritation Potential of Leaf Extracts Measured by the HET–CAM Assay
2.7. Antimicrobial Activity
2.7.1. Minimum Inhibitory Concentration (MIC)
2.7.2. Disc Diffusion Test
3. Materials and Methods
3.1. Chemicals
3.2. Sample Digestion
3.3. Instrumentation and Quantification of Minerals
3.4. Preparation of Plant Extracts
3.5. Determination of Total Phenolic Content
3.6. Estimation of Total Flavonoid Content
3.7. Estimation of Phenolic Compounds by Liquid Chromatography-Mass Spectrometry/Mass Spectrometry (LC-MS/MS)
3.8. Antioxidant Activity
3.8.1. Evaluation of the 1,1-Diphenyl–2-Picrylhydrazyl (DPPH) Radical Scavenging Assay
3.8.2. Evaluation of the 2,2′-Azino-bis-3-Ethylbenzthiazoline-6-Sulphonic Acid (ABTS) Assay
3.9. Cytotoxicity
3.10. Assessment of Irritation Potential of L. chinense Leaf Extracts in a Fertile Chicken Egg
3.11. In Vitro Assay for Antimicrobial Activity
3.11.1. Disc diffusion Method
3.11.2. Minimum Inhibitory Concentration (MIC)
3.12. Statistical Analysis
Author Contributions
Funding
Acknowledgments
Conflicts of Interest
References
- Negi, P.; Jayaprakasha, G.; Jena, B. Antioxidant and antimutagenic activities of pomegranate peel extracts. Food Chem. 2003, 80, 393–397. [Google Scholar] [CrossRef]
- Zahin, M.; Aqil, F.; Ahmad, I. Broad spectrum antimutagenic activity of antioxidant active fraction of Punica granatum L. peel extracts. Mutat. Res. Toxicol. Environ. Mutagen. 2010, 703, 99–107. [Google Scholar] [CrossRef] [PubMed]
- Edward-Jones, V.; Rai, M.K.; Kon, K.V. Alternative antimicrobial approaches to fighting multidrug-resistant infections. In Fighting Multidrug Resistance with Herbal Extracts, Essential Oils and Their Components; Academic Press: Amsterdam, The Netherlands, 2013; Volume 1, pp. 1–8. [Google Scholar]
- Aras, A.; Dogru, M.; Bursal, E. Determination of antioxidant potential of Nepeta nuda subsp. lydiae. Anal. Chem. Lett. 2016, 6, 758–765. [Google Scholar] [CrossRef]
- Olalere, O.A.; Abdurahman, N.H.; Yunus, R.B.M.; Alara, O.R.; Ahmad, M.M.; Abayomi, O.O.; Nour, A.H.; Ruth, A.O. Mineral element determination and phenolic compounds profiling of oleoresin extracts using an accurate mass LC-MS-QTOF and ICP-MS. J. King Saud. Univ. Sci. 2019, 31, 859–863. [Google Scholar] [CrossRef]
- Sofo, A.; Lundegårdh, B.; Mårtensson, A.; Manfra, M.; Pepe, G.; Sommella, E.; De Nisco, M.; Tenore, G.C.; Campiglia, P.; Scopa, A. Different agronomic and fertilization systems affect polyphenolic profile, antioxidant capacity and mineral composition of lettuce. Sci. Hortic. 2016, 204, 106–115. [Google Scholar] [CrossRef]
- Liu, X.; Ardo, S.; Bunning, M.; Parry, J.; Zhou, K.; Stushnoff, C.; Stoniker, F.; Yu, L.; Kendall, P. Total phenolic content and DPPH radical scavenging activity of lettuce (Lactuca sativa L.) grown in Colorado. LWT 2007, 40, 552–557. [Google Scholar] [CrossRef]
- Szymczycha-Madeja, A.; Welna, M.; Pohl, P. Elemental analysis of teas and their infusions by spectrometric methods. TrAC Trends Anal. Chem. 2012, 35, 165–181. [Google Scholar] [CrossRef]
- Yanai, N.; Shiotani, S.; Hagiwara, S.; Nabetani, H.; Nakajima, M. Antioxidant Combination Inhibits Reactive Oxygen Species Mediated Damage. Biosci. Biotechnol. Biochem. 2008, 72, 3100–3106. [Google Scholar] [CrossRef][Green Version]
- Yokel, R.A.; Florence, R.L. Aluminum bioavailability from tea infusion. Food Chem. Toxicol. 2008, 46, 3659–3663. [Google Scholar] [CrossRef]
- Michalak, A. Phenolic compounds and their antioxidant activity in plants growing under heavy metal stress. Pol. J. Environ. Stud. 2006, 15, 523–530. [Google Scholar]
- Abu-Darwish, M.S.; Abu-Dieyeh, Z.H.; Mufeed, B.; Al-Tawaha, A.R.M.; Al-Dalain, S.Y.A. Trace element contents and essential oil yields from wild thyme plant (Thymus serpyllum L.) grown at different natural variable environments, Jordan. J. Food Agric. Environ. 2009, 7, 920–924. [Google Scholar]
- Nuapia, Y.; Chimuka, L.; Cukrowska, E. Assessment of heavy metals in raw food samples from open markets in two African cities. Chemosphere 2018, 196, 339–346. [Google Scholar] [CrossRef]
- Kozarski, M.; Klaus, A.S.; Jakovljevic, D.; Todorovic, N.; Vunduk, J.; Petrovic, P.; Niksic, M.; Vrvić, M.; Van Griensven, L.J. Antioxidants of edible mushrooms. Molecules 2015, 20, 19489–19525. [Google Scholar] [CrossRef] [PubMed]
- Velioglu, Y.S.; Mazza, G.; Gao, L.; Oomah, B.D. Antioxidant activity and total phenolics in selected fruits, vegetables, and grain products. J. Agric. Food Chem. 1998, 46, 4113–4117. [Google Scholar] [CrossRef]
- Safer, A.M.; Al-Nughamish, A.J. Hepatotoxicity induced by the anti-oxidant food additive, butylated hydroxytoluene (BHT), in rats: An electron microscopical study. Histol. Histopathol. 1999, 14, 391–406. [Google Scholar] [PubMed]
- Schuenzel, K.M.; Harrison, M.A. Microbial antagonists of foodborne pathogens on fresh, minimally processed vegetables. J. Food Prot. 2002, 65, 1909–1915. [Google Scholar] [CrossRef] [PubMed]
- Sokmen, A.; Gulluce, M.; Akpulat, H.A.; Daferera, D.; Tepe, B.; Polissiou, M.; Sokmen, M.; Şahin, F. The in vitro antimicrobial and antioxidant activities of the essential oils and methanol extracts of endemic Thymus spathulifolius. Food Control. 2004, 15, 627–634. [Google Scholar] [CrossRef]
- Tepe, B.; Daferera, D.; Sökmen, M.; Polissiou, A.M.; Sökmen, A. In Vitro antimicrobial and antioxidant activities of the essential oils and various extracts of Thymus eigiiM. Zohary et P.H. Davis. J. Agric. Food Chem. 2004, 52, 1132–1137. [Google Scholar] [CrossRef]
- Paphitou, N.I. Antimicrobial resistance: Action to combat the rising microbial challenges. Int. J. Antimicrob. Agents 2013, 42, S25–S28. [Google Scholar] [CrossRef]
- Myers, L.P.; Fan, R.; Zheng, Q.; Pruett, S.B. Sodium methyldithiocarbamate causes thymic atrophy by an indirect mechanism of corticosterone up-regulation. J. Immunotoxicol. 2005, 2, 97–106. [Google Scholar] [CrossRef]
- Kim, J.-S.; Chung, H.Y. GC-MS analysis of the volatile components in dried boxthorn (Lycium chinensis) Fruit. J. Korean Soc. Appl. Boil. Chem. 2009, 52, 516–524. [Google Scholar] [CrossRef]
- Potterat, O. Goji (Lycium barbarum and L. chinense): Phytochemistry, pharmacology and safety in the perspective of traditional uses and recent popularity. Planta Medica 2009, 76, 7–19. [Google Scholar] [CrossRef] [PubMed]
- Lin, C.; Chuang, S.; Lin, J.; Yang, J. Evaluation of the antiinflammatory hepatoprotective and antioxidant activities of Lycium chinense from Taiwan. Phytomedicine 1997, 4, 213–220. [Google Scholar] [CrossRef]
- Chin, Y.W.; Lim, S.W.; Kim, S.H.; Shin, D.Y.; Suh, Y.G.; Kim, Y.B.; Kim, Y.C.; Kim, J. Hepatoprotective pyrrole derivatives of Lycium chinense fruits. Bioorg. Med. Chem. Lett. 2003, 13, 79–81. [Google Scholar] [CrossRef]
- Kim, S.Y.; Choi, Y.-H.; Huh, H.; Kim, J.; Kim, Y.C.; Lee, H.S. New antihepatotoxic cerebroside from Lyciumchinense fruits. J. Nat. Prod. 1997, 60, 274–276. [Google Scholar] [CrossRef] [PubMed]
- Ionica, M.E.; Nour, V.; Trandafir, I. Polyphenols content and antioxidant capacity of goji fruits (Lycium chinense) as affected by the extraction solvents. South West. J. Hortic. Biol. Environ. 2012, 3, 121–129. [Google Scholar]
- Kim, J.S. Comparison of antioxidant properties of water and ethanol extracts obtained from dried boxthorn (Lycium chinensis) fruit. Food Nutr. Sci. 2012, 3, 1307–1320. [Google Scholar]
- Liu, S.-C.; Lin, J.-T.; Hu, C.-C.; Shen, B.-Y.; Chen, T.-Y.; Chang, Y.-L.; Shih, C.-H.; Yang, D.-J. Phenolic compositions and antioxidant attributes of leaves and stems from three inbred varieties of Lycium chinense Miller harvested at various times. Food Chem. 2017, 215, 284–291. [Google Scholar] [CrossRef]
- Zhang, J.-X.; Guan, S.-H.; Feng, R.-H.; Wang, Y.; Wu, Z.-Y.; Zhang, Y.-B.; Chen, X.-H.; Bi, K.-S.; Guo, D.-A. Neolignanamides, lignanamides, and other phenolic compounds from the root bark of Lycium chinense. J. Nat. Prod. 2013, 76, 51–58. [Google Scholar] [CrossRef]
- Liu, C.L.; Chen, Y.S.; Yang, J.H.; Chiang, B.H.; Hsu, C.K. Trace element water iproves the antioxidant activity of Buckwheat (Fagopyrum esculentum Moench) sprouts. J. Agric. Food Chem. 2007, 55, 8934–8940. [Google Scholar] [CrossRef]
- Da Silva, A.L.O.; Barrocas, P.R.G.; Jacob, S.D.C.; Moreira, J.C. Dietary intake and health effects of selected toxic elements. Braz. J. Plant Physiol. 2005, 17, 79–93. [Google Scholar] [CrossRef]
- Perna, A.M.; Simonetti, A.; Intaglietta, I.; Sofo, A.; Gambacorta, E. Metal content of southern Italy honey of different botanical origins and its correlation with polyphenol content and antioxidant activity. Int. J. Food Sci. Technol. 2012, 47, 1909–1917. [Google Scholar] [CrossRef]
- Solayman, M.; Islam, A.; Paul, S.; Ali, Y.; Khalil, I.; Alam, N.; Gan, S.H. Physicochemical properties, minerals, trace elements, and heavy metals in honey of different origins: A comprehensive review. Compr. Rev. Food Sci. Food Saf. 2015, 15, 219–233. [Google Scholar] [CrossRef]
- Fukai, T.; Ushio-Fukai, M. Superoxide dismutases: Role in redox signaling, vascular function, and diseases. Antioxid. Redox Signal. 2011, 15, 1583–1606. [Google Scholar] [CrossRef] [PubMed]
- Bursal, E. Kinetic properties of peroxidase enzyme from chard (Beta vulgaris Subspeciescicla) leaves. Int. J. Food Prop. 2013, 16, 1293–1303. [Google Scholar] [CrossRef]
- Bingol, M.N.; Bursal, E. LC-MS/MS analysis of phenolic compounds and in vitro antioxidant potential of stachys lavandulifolia vahl. var. brachydon boiss. Int. Lett. Nat. Sci. 2018, 72, 28–36. [Google Scholar] [CrossRef]
- Nishimura, F.D.C.Y.; De Almeida, A.C.; Ratti, B.A.; Ueda-Nakamura, T.; Nakamura, C.V.; Ximenes, V.F.; Silva, S.D.O. Antioxidant effects of quercetin and naringenin are associated with impaired neutrophil microbicidal activity. Evid. Based Complement. Altern. Med. 2013, 2013, 1–7. [Google Scholar] [CrossRef]
- Parhiz, H.; Roohbakhsh, A.; Soltani, F.; Rezaee, R.; Iranshahi, M. Antioxidant and anti-inflammatory properties of the citrus flavonoids hesperidin and hesperetin: An updated review of their molecular mechanisms and experimental models. Phytother. Res. 2014, 29, 323–331. [Google Scholar] [CrossRef]
- Kamalakkannan, N.; Prince, P.S.M. Antihyperglycaemic and antioxidant effect of rutin, a polyphenolic flavonoid, in streptozotocin-induced diabetic wistar rats. Basic Clin. Pharmacol. Toxicol. 2006, 98, 97–103. [Google Scholar] [CrossRef]
- Kikuzaki, H.; Hisamoto, M.; Hirose, K.; Akiyama, K.; Taniguchi, H. Antioxidant properties of ferulic acid and its related compounds. J. Agric. Food Chem. 2002, 50, 2161–2168. [Google Scholar] [CrossRef]
- Amarowicz, R.; Pegg, R.; Rahimi-Moghaddam, P.; Barl, B.; Weil, J. Free-radical scavenging capacity and antioxidant activity of selected plant species from the canadian prairies. Food Chem. 2004, 84, 551–562. [Google Scholar] [CrossRef]
- Balasundram, N.; Sundram, K.; Samman, S. Phenolic compounds in plants and agri-industrial by-products: Antioxidant activity, occurrence, and potential uses. Food Chem. 2006, 99, 191–203. [Google Scholar] [CrossRef]
- Zhang, H.-Y.; Sun, Y.-M.; Wang, X.-L. Substituent effects on O—H bond dissociation enthalpies and ionization potentials of catechols: A DFT study and its implications in the rational design of phenolic antioxidants and elucidation of structure–activity relationships for flavonoid antioxidants. Chem. Eur. J. 2003, 9, 502–508. [Google Scholar] [CrossRef] [PubMed]
- Moghaddam, M.; Mehdizadeh, L. Variability of total phenolic, flavonoid and rosmarinic acid content among Iranian basil accessions. LWT 2015, 63, 535–540. [Google Scholar] [CrossRef]
- Neuhouser, M.L. Flavonoids and cancer prevention: What is the evidence in humans? Pharm. Biol. 2004, 42, 36–45. [Google Scholar] [CrossRef]
- Mokrani, A.; Madani, K. Effect of solvent, time and temperature on the extraction of phenolic compounds and antioxidant capacity of peach (Prunus persica L.) fruit. Sep. Purif. Technol. 2016, 162, 68–76. [Google Scholar] [CrossRef]
- Li, F.; Li, S.; Li, H.-B.; Deng, G.-F.; Ling, W.-H.; Xu, X.-R. Antiproliferative activities of tea and herbal infusions. Food Funct. 2013, 4, 530. [Google Scholar] [CrossRef]
- Fontes, S.T.; Fernández, M.R.; Ogliari, F.A.; De Carvalho, R.V.; Moraes, R.R.; Pinto, M.B.; Piva, E. Tetrahydrofuran as solvent in dental adhesives: Cytotoxicity and dentin bond stability. Clin. Oral Investig. 2012, 17, 237–242. [Google Scholar] [CrossRef]
- Georgiev, K.D.; Slavov, I.J.; Iliev, I. Synergistic growth inhibitory effects of Lycium barbarum (Goji berry) extract with doxorubicin against human breast cancer cells. J. Pharm. Pharmacol. Res. 2019, 3, 51–58. [Google Scholar] [CrossRef]
- Rahal, A.; Kumar, A.; Singh, V.; Yadav, B.; Tiwari, R.; Chakraborty, S.; Dhama, K. Oxidative stress, prooxidants and antioxidants: The interplay. BioMed Res. Int. 2014, 2014, 1–19. [Google Scholar] [CrossRef]
- Estevinho, L.M.; Pereira, A.; Moreira, L.F.; Dias, L.G.; Pereira, E.L. Antioxidant and antimicrobial effects of phenolic compounds extracts of Northeast Portugal honey. Food Chem. Toxicol. 2008, 46, 3774–3779. [Google Scholar] [CrossRef] [PubMed]
- Aleksic, V.; Knezevic, P. Antimicrobial and antioxidative activity of extracts and essential oils of Myrtus communis L. Microbiol. Res. 2014, 169, 240–254. [Google Scholar] [CrossRef] [PubMed]
- Llorent-Martínez, E.J.; Ortega-Barrales, P.; Panneerselvam, C.; Mocan, A.; Simirgiotis, M.; Ceylan, R.; Uysal, S.; Aktumsek, A. Evaluation of antioxidant potential, enzyme inhibition activity and phenolic profile of Lathyrus cicera and Lathyrus digitatus: Potential sources of bioactive compounds for the food industry. Food Chem. Toxicol. 2017, 107, 609–619. [Google Scholar] [CrossRef] [PubMed]
- Araújo, K.C.F.; Costa, E.M.D.M.; Pazini, F.; Valadares, M.C.; De Oliveira, V. Bioconversion of quercetin and rutin and the cytotoxicity activities of the transformed products. Food Chem. Toxicol. 2013, 51, 93–96. [Google Scholar] [CrossRef] [PubMed]
- Bonechi, C.; Donati, A.; Leone, G.; Consumi, M.; Lamponi, S.; Tamasi, G.; Rossi, C.; Magnani, A. Protective effect of quercetin and rutin encapsulated liposomes on induced oxidative stress. Biophys. Chem. 2018, 233, 55–63. [Google Scholar] [CrossRef]
- Tamasi, G.; Baratto, M.C.; Bonechi, C.; Byelyakova, A.; Pardini, A.; Donati, A.; Leone, G.; Consumi, M.; Lamponi, S.; Magnani, A.; et al. Chemical characterization and antioxidant properties of products and by-products from Olea europaea L. Food Sci. Nutr. 2019, 7, 2907–2920. [Google Scholar] [CrossRef]
- Danihelova, M.; Veverka, M.; Šturdík, E.; Jantova, S. Antioxidant action and cytotoxicity on HeLa and NIH-3T3 cells of new quercetin derivatives. Interdiscip. Toxicol. 2013, 6, 209–216. [Google Scholar] [CrossRef]
- Lokman, N.A.; Elder, A.S.F.; Ricciardelli, C.; Oehler, M.K. Chick chorioallantoic membrane (CAM) assay as an in vivo model to study the effect of newly identified molecules on ovarian cancer invasion and metastasis. Int. J. Mol. Sci. 2012, 13, 9959–9970. [Google Scholar] [CrossRef]
- Zheng, W.; Wang, S.Y. Antioxidant activity and phenolic compounds in selected herbs. J. Agric. Food Chem. 2001, 49, 5165–5170. [Google Scholar] [CrossRef]
- Saavedra, M.J.; Borges, A.; Dias, C.; Aires, A.; Bennett, R.N.; Rosa, E.; Simões, M. Antimicrobial activity of phenolics and glucosinolate hydrolysis products and their synergy with streptomycin against pathogenic bacteria. Med. Chem. 2010, 6, 174–183. [Google Scholar] [CrossRef]
- Hirai, I.; Okuno, M.; Katsuma, R.; Arita, N.; Tachibana, M.; Yamamoto, Y. Characterisation of anti-Staphylococcus aureus activity of quercetin. Int. J. Food Sci. Technol. 2010, 45, 1250–1254. [Google Scholar] [CrossRef]
- Cueva, C.; Moreno-Arribas, M.V.; Martin-Álvarez, P.J.; Bills, G.F.; Vicente, M.F.; Basilio, A.; Rivas, C.L.; Requena, T.; Rodríguez, J.M.; Bartolomé, B. Antimicrobial activity of phenolic acids against commensal, probiotic and pathogenic bacteria. Res. Microbiol. 2010, 161, 372–382. [Google Scholar] [CrossRef] [PubMed]
- Liang, Y.; Xu, Q.; Xie, H.; Zhou, Y.; Wei, X. Chemical constituents from mango seed kernels and their antimicrobial activity. J. Trop. Subtrop. Bot. 2010, 18, 445–448. [Google Scholar]
- Lou, Z.; Wang, H.; Zhu, S.; Ma, C.; Wang, Z. Antibacterial activity and mechanism of action of chlorogenic acid. J. Food Sci. 2011, 76, 398. [Google Scholar] [CrossRef] [PubMed]
- Singleton, V.L.; Rossi, J.A., Jr. Colorimetry of total phenolics with phosphomolybdic-phosphotungstic acid reagents. Am. J. Enol. Vitic. 1965, 16, 144–158. [Google Scholar]
- Moreno, M.I.; Isla, M.I.; Sampietro, A.R.; Vattuone, M.A. Comparison of the free radical-scavenging activity of propolis from several regions of Argentina. J. Ethnopharmacol. 2000, 71, 109–114. [Google Scholar] [CrossRef]
- Chung, I.-M.; Chelliah, R.; Oh, D.-H.; Kim, S.-H.; Yu, C.Y.; Ghimire, B.K. Tupistra nutans wall. root extract, rich in phenolics, inhibits microbial growth and α-glucosidase activity, while demonstrating strong antioxidant potential. Braz. J. Bot. 2019, 42, 383–397. [Google Scholar] [CrossRef]
- Xiong, Q.; Kadota, S.; Tani, T.; Namba, T. Antioxidative effects of phenylethanoids from cistanche deserticola. Boil. Pharm. Bull. 1996, 19, 1580–1585. [Google Scholar] [CrossRef]
- Thaipong, K.; Boonprakob, U.; Crosby, K.; Cisneros-Zevallos, L.; Byrne, D.H. Comparison of ABTS, DPPH, FRAP, and ORAC assays for estimating antioxidant activity from guava fruit extracts. J. Food Compos. Anal. 2006, 19, 669–675. [Google Scholar] [CrossRef]
- Sandra, F.; Sudiono, J.; Trisfilha, P.; Pratiwi, D. Cytotoxicity of Alpinia galanga rhizome crude extract on NIH-3T3 cells. Indones. Biomed. J. 2017, 9, 23. [Google Scholar] [CrossRef]
- Rios, J.; Recio, M. Medicinal plants and antimicrobial activity. J. Ethnopharmacol. 2005, 100, 80–84. [Google Scholar] [CrossRef] [PubMed]
- Kobayashi, M.; Kakizono, T.; Nagai, S. Enhanced carotenoid biosynthesis by oxidative stress in acetate-induced cyst cells of a green unicellular alga, Haematococcus pluvialis. Appl. Environ. Microbiol. 1993, 59, 867–873. [Google Scholar] [CrossRef] [PubMed]

| Element | Concentration a (mg L−1) | Linearity (r2) | Slope (S) | Response SD | RSD c (%) | LOD b LOQ b | |
|---|---|---|---|---|---|---|---|
| µg mL−1 | |||||||
| Al | 0.5–10 | 0.999932 | 3730 | 358.88 | 0.96 | 0.288643 | 0.962145 |
| As | 0.5–10 | 0.999876 | 47.10 | 3.54 | 0.75 | 0.225478 | 0.751592 |
| Ba | 0.5–10 | 0.999825 | 5071 | 505.09 | 0.99 | 0.298811 | 0.996036 |
| Bi | 0.5–10 | 0.999907 | 286.5 | 38.39 | 1.34 | 0.401990 | 1.339965 |
| Ca | 0.5–10 | 0.999576 | 8157 | 1103.17 | 1.15 | 0.405726 | 1.352421 |
| Cd | 0.5–10 | 0.999812 | 2007 | 156.53 | 0.78 | 0.233976 | 0.779920 |
| Co | 0.5–10 | 0.999131 | 1197 | 111.51 | 0.93 | 0.279474 | 0.931579 |
| Cr | 0.5–10 | 0.999841 | 4921 | 522.49 | 1.06 | 0.318527 | 1.061756 |
| Cu | 0.5–10 | 0.999852 | 19,530 | 1778.00 | 0.91 | 0.273118 | 0.910394 |
| Fe | 0.5–10 | 0.999803 | 4031 | 352.03 | 0.87 | 0.261992 | 0.873307 |
| Li | 0.5–10 | 0.999783 | 32,120 | 3995.40 | 1.24 | 0.373169 | 1.243898 |
| Mg | 0.5–10 | 0.999738 | 19,920 | 2106.85 | 0.94 | 0.317297 | 1.057656 |
| Mn | 0.5–10 | 0.999901 | 31,120 | 3071.07 | 0.98 | 0.296054 | 0.986848 |
| Ni | 0.5–10 | 0.999757 | 1951 | 174.43 | 0.89 | 0.268216 | 0.894054 |
| Pb | 0.5–10 | 0.999792 | 277.0 | 37.92 | 1.37 | 0.410686 | 1.368953 |
| Se | 0.5–10 | 0.999913 | 72.12 | 8.72 | 1.21 | 0.362729 | 1.209096 |
| Ag | 0.5–10 | 0.999942 | 20,240 | 1753.28 | 0.86 | 0.259874 | 0.866245 |
| Ti | 0.5–10 | 0.999927 | 38,130 | 2907.65 | 0.76 | 0.228769 | 0.762562 |
| Zn | 0.5–10 | 0.999799 | 5112 | 378.98 | 0.74 | 0.222406 | 0.741354 |
| Element | Concentration (µg mL−1) |
|---|---|
| Al | 0.389 ± 0.0053 |
| As | 0.046 ± 0.0319 |
| Ba | 0.048 ± 0.0023 |
| Bi | 0.062 ± 0.0197 |
| Ca | 69.17 ± 0.5610 |
| Cd | 0.088 ± 0.0004 |
| Co | 0.133 ± 0.0025 |
| Cr | 0.094 ± 0.0012 |
| Cu | 0.016 ± 0.0017 |
| Fe | 0.028 ± 0.0028 |
| Li | 0.038 ± 0.0010 |
| Mg | 15.40 ± 0.1040 |
| Mn | 0.345 ± 0.0025 |
| Ni | 0.110 ± 0.0019 |
| Pb | 0.043 ± 0.0015 |
| Se | 0.161 ± 0.0823 |
| Ag | 0.052 ± 0.0823 |
| Ti | 0.050 ± 0.0002 |
| Zn | 0.041 ± 0.0031 |
| Assays | Al | As | Ba | Bi | Ca | Cd | Co | Cr | Cu | Fe | Li | Mg | Mn | Ni | Pb | Se | Ag | Ti | Zn |
|---|---|---|---|---|---|---|---|---|---|---|---|---|---|---|---|---|---|---|---|
| DPPH | −0.724 | 0.999 * | 0.999 * | 0.989 | 0.995 | 0.993 | 0.927 | 0.999 * | 0.989 | 0.989 | 0.989 | 0.999 * | 0.989 | 0.989 | 0.989 | 0.994 | 0.241 | 0.995 | 0.865 |
| ABTS | −0.753 | 0.997 | 0.997 | 0.994 | 0.989 | 0.986 | 0.943 | 0.997 | 0.994 | 0.994 | 0.994 | 0.997 | 0.994 | 0.994 | 0.994 | 0.998 * | 0.283 | 0.989 | 0.842 |
| TPC | −0.700 | 0.972 ** | 0.981 ** | 0.983 | 0.998 * | 0.996 | 0.914 | 0.900 ** | 0.983 | 0.983 | 0.983 | 0.990 ** | 0.983 | 0.983 | 0.983 | 0.990 | 0.208 | 0.998 * | 0.882 |
| TFC | −0.798 | 0.988 | 0.988 | 0.999 * | 0.976 | 0.972 | 0.964 | 0.988 | 0.999 * | 0.999 * | 0.999 * | 0.988 | 0.999 * | 0.999 * | 0.999 * | 0.980 ** | 0.351 | 0.976 | 0.802 |
| Assays | Extracts | Control | |
|---|---|---|---|
| BHT | Ascorbic Acid | ||
| DPPH * (IC50) | 70.99 ± 7.95 | 34.00 ± 1.00 | |
| ABTS * (IC50) | 1772.31 ± 10.87 | 100.05 ± 3.50 | |
| TPC (mgGAE/g) | 7.55 ± 0.22 | ||
| TFC (mgQE/g) | 0.02 ± 0.001 | ||
| Phenolic Compounds | Retention Time | Q1 (m/z) a | Q3 (m/z) b | DP (V) c | EP (V) d | CEP (V) e | CE (eV) f | CXP (V) g | Phenolic Compounds (µg/g Dry Weight of Leaf Extract) |
|---|---|---|---|---|---|---|---|---|---|
| Protocatechuic acid | 8.04 | 152.896 | 108.900 | −16.000 | −9.000 | −10.000 | −22.000 | −6.000 | 1198.70 ± 5.00 |
| Chlorogenic acid | 8.30 | 352.846 | 191.000 | −21.000 | −7.000 | −32.000 | −30.000 | −10.000 | 192.30 ± 4.50 |
| Rutin | 9.58 | 609.002 | 299.700 | −91.000 | −10.500 | −34.000 | −52.000 | −14.000 | 119.70 ± 2.50 |
| p-Hydroxybenzoic acid | 10.02 | 136.885 | 92.900 | −16.000 | −8.500 | −12.000 | −24.000 | −6.000 | 529.70 ± 6.15 |
| Caffeic acid | 10.10 | 178.868 | 134.800 | −16.000 | −8.000 | −14.000 | −22.000 | −6.000 | 67.60 ± 2.00 |
| Gentisic acid | 10.63 | 152.871 | 107.900 | −16.000 | −8.500 | −6.000 | −28.000 | −22.000 | 147.90 ± 3.00 |
| p-Coumaric acid | 12.08 | 162.866 | 118.900 | −11.000 | −7.000 | −14.000 | −20.000 | −6.000 | 466.90 ± 6.50 |
| Salicylic acid | 16.58 | 136.874 | 92.900 | −16.000 | −7.500 | −12.000 | −22.000 | −6.000 | 134.30 ± 3.00 |
| ABTS | DPPH | TPC | TFC | Protocate- Chuic Acid | Chlorogenic Acid | Rutin | p-Hydroxy- Benzoic Acid | Caffeic Acid | Gentisic Acid | p-Coumaric Acid | Salicylic Acid | |
|---|---|---|---|---|---|---|---|---|---|---|---|---|
| ABTS | 1 | 0.999 * | 0.997 * | 0.997 * | 0.997 * | 0.949 | 0.990 | 0.999 * | 0.997 | 0.999 * | 0.999 * | 0.969 |
| DPPH | 0.999 * | 1 | 0.999 * | 0.993 | 0.993 | 0.934 | 0.991 | 0.997 | 0.999 * | 0.997 * | 0.998 ** | 0.957 |
| Phenolic Compounds | Cytotoxicity |
|---|---|
| Protocatechuic acid | 0.957 ** |
| Chlorogenic acid | 0.998 * |
| Rutin | 0.870 |
| p-Hydroxybenzoic acid | 0.872 |
| Caffeic acid | 0.919 |
| Gentisic acid | 0. 819 |
| p-Coumaric acid | 0.984 * |
| Salicylic acid | 0.998 * |
| Samples | Irritation Score | Irritation Assessment |
|---|---|---|
| Negative control | 0 | Non-irritant |
| NaOH (0.1 M) | 18.82 | Strong irritant |
| Leaf extracts (50 mg/mL) | 0 | Non-irritant |
| Bacterial Strains | -------MIC (ppm)----- |
|---|---|
| B. cereus | 625 |
| K. pneumoniae | >1000 |
| S. aureus | 625 |
| S. typhimurium | >1000 |
| B. subtilis | >1000 |
| E. coli | 155 |
| H. pylori | 625 |
| Bacterial Strains | Leaf Extracts | Tetracycline (10 mg) |
|---|---|---|
| -----------Zone of Inhibition (cm)--------- | ||
| B. cereus | 1.4 | 1.6 |
| K. pneumoniae | 0.5 | 0.8 |
| S. aureus | 0.9 | 2.0 |
| S. typhimurium | 0.9 | 1.1 |
| B. subtilis | 1.2 | 1.2 |
| E. coli | 1.8 | 1.9 |
| H. pylori | 1.7 | 1.8 |
© 2020 by the authors. Licensee MDPI, Basel, Switzerland. This article is an open access article distributed under the terms and conditions of the Creative Commons Attribution (CC BY) license (http://creativecommons.org/licenses/by/4.0/).
Share and Cite
Thiruvengadam, M.; Ghimire, B.K.; Kim, S.-H.; Yu, C.Y.; Oh, D.-H.; Chelliah, R.; Kwon, C.; Kim, Y.-J.; Chung, I.M. Assessment of Mineral and Phenolic Profiles and Their Association with the Antioxidant, Cytotoxic Effect, and Antimicrobial Potential of Lycium chinense Miller. Plants 2020, 9, 1023. https://doi.org/10.3390/plants9081023
Thiruvengadam M, Ghimire BK, Kim S-H, Yu CY, Oh D-H, Chelliah R, Kwon C, Kim Y-J, Chung IM. Assessment of Mineral and Phenolic Profiles and Their Association with the Antioxidant, Cytotoxic Effect, and Antimicrobial Potential of Lycium chinense Miller. Plants. 2020; 9(8):1023. https://doi.org/10.3390/plants9081023
Chicago/Turabian StyleThiruvengadam, Muthu, Bimal Kumar Ghimire, Seung-Hyun Kim, Chang Yeon Yu, Deog-Hwan Oh, Ramachandran Chelliah, Chang Kwon, Yun-Ju Kim, and Ill Min Chung. 2020. "Assessment of Mineral and Phenolic Profiles and Their Association with the Antioxidant, Cytotoxic Effect, and Antimicrobial Potential of Lycium chinense Miller" Plants 9, no. 8: 1023. https://doi.org/10.3390/plants9081023
APA StyleThiruvengadam, M., Ghimire, B. K., Kim, S.-H., Yu, C. Y., Oh, D.-H., Chelliah, R., Kwon, C., Kim, Y.-J., & Chung, I. M. (2020). Assessment of Mineral and Phenolic Profiles and Their Association with the Antioxidant, Cytotoxic Effect, and Antimicrobial Potential of Lycium chinense Miller. Plants, 9(8), 1023. https://doi.org/10.3390/plants9081023

